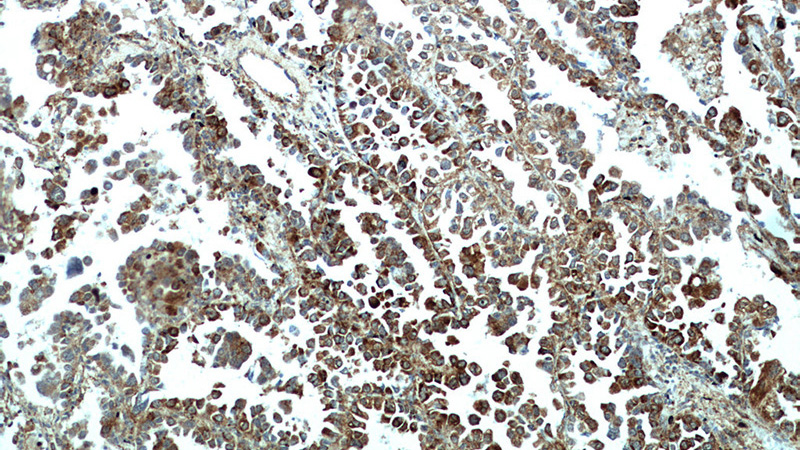
Immunohistochemical of paraffin-embedded human lung cancer using Catalog No:112748(MPP3 antibody) at dilution of 1:50 (under 10x lens)
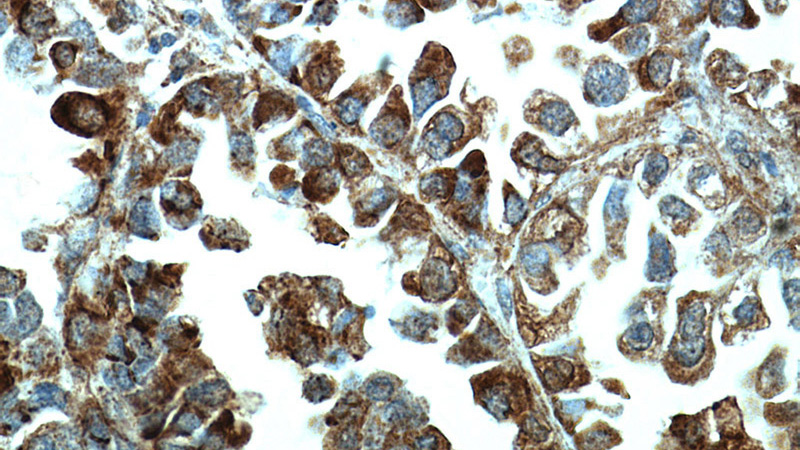
Immunohistochemical of paraffin-embedded human lung cancer using Catalog No:112748(MPP3 antibody) at dilution of 1:50 (under 40x lens)

-
Product Name
MPP3 antibody
- Documents
-
Description
MPP3 Rabbit Polyclonal antibody. Positive IHC detected in human lung cancer tissue. Positive WB detected in Transfected HEK-293 cells.
-
Tested applications
ELISA, IHC, WB
-
Species reactivity
Human,Mouse,Rat; other species not tested.
-
Alternative names
Discs large homolog 3 antibody; DLG3 antibody; MAGUK p55 subfamily member 3 antibody; MPP3 antibody; Protein MPP3 antibody
- Immunogen
-
Isotype
Rabbit IgG
-
Preparation
This antibody was obtained by immunization of MPP3 recombinant protein (Accession Number: XM_006721915). Purification method: Antigen affinity purified.
-
Clonality
Polyclonal
-
Formulation
PBS with 0.1% sodium azide and 50% glycerol pH 7.3.
-
Storage instructions
Store at -20℃. DO NOT ALIQUOT
-
Applications
Recommended Dilution:
WB: 1:500-1:5000
IHC: 1:20-1:200
-
Validations
Immunohistochemical of paraffin-embedded human lung cancer using Catalog No:112748(MPP3 antibody) at dilution of 1:50 (under 10x lens)
Immunohistochemical of paraffin-embedded human lung cancer using Catalog No:112748(MPP3 antibody) at dilution of 1:50 (under 40x lens)

Transfected HEK-293 cells were subjected to SDS PAGE followed by western blot with Catalog No:112748(MPP3 Antibody) at dilution of 1:1000
-
Background
MPP3, also named as DLG3, belongs to the MAGUK family which interact with the cytoskeleton and regulate cell proliferation, signaling pathways, and intracellular junctions. MPP3 plays an important role in signal transduction.
-
References
- Dudok JJ, Sanz AS, Lundvig DM, Wijnholds J. MPP3 is required for maintenance of the apical junctional complex, neuronal migration, and stratification in the developing cortex. The Journal of neuroscience : the official journal of the Society for Neuroscience. 33(19):8518-27. 2013.
- Park B, Alves CH, Lundvig DM. PALS1 is essential for retinal pigment epithelium structure and neural retina stratification. The Journal of neuroscience : the official journal of the Society for Neuroscience. 31(47):17230-41. 2011.
Related Products / Services
Please note: All products are "FOR RESEARCH USE ONLY AND ARE NOT INTENDED FOR DIAGNOSTIC OR THERAPEUTIC USE"
